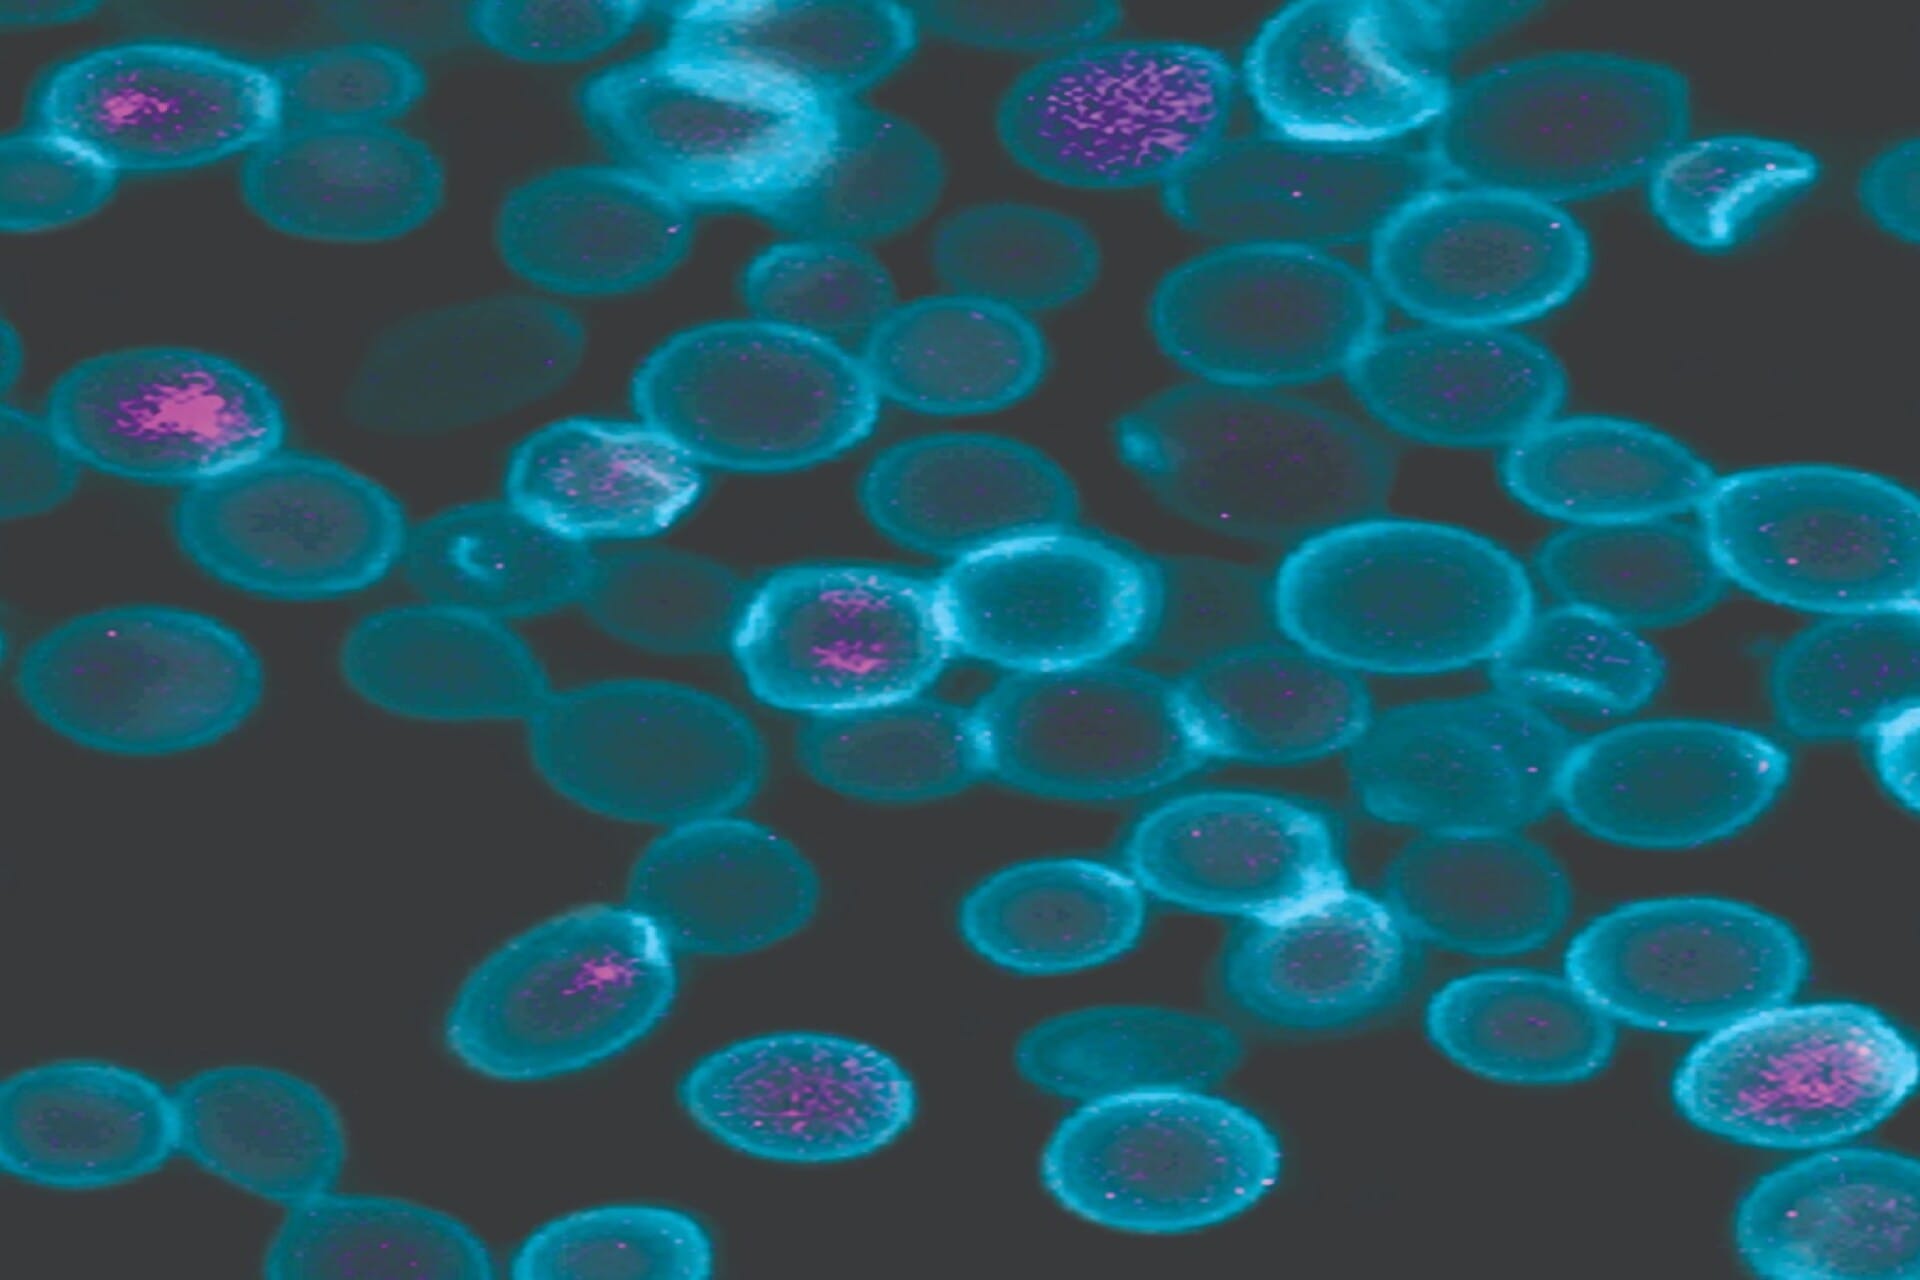

In a groundbreaking scientific revelation, researchers have recorded an extraordinary phenomenon: a massive particle has seemingly passed through the Earth, potentially representing the first detection of dark matter. This encounter not only has the potential to reshape our comprehension of the cosmos but also fundamentally challenges existing paradigms in physics.
Dark matter has been a prominent enigma in astrophysics for decades, constituting approximately 27% of the universe’s total mass-energy content. Unlike ordinary matter, which is composed of atoms and can interact with light, dark matter does not emit, absorb, or reflect electromagnetic radiation, making its detection profoundly challenging. As a result, dark matter’s existence has primarily been inferred through gravitational effects observed in galaxies and cosmic structures.
The recent event was triggered when a team of scientists engaged in an extensive research program aimed at uncovering the elusive particles that comprise dark matter. Their efforts centered around high-energy detectors strategically placed underground, which are designed to catch and analyze potential interactions between dark matter candidates and ordinary matter. When one of these detectors recorded an unexpected signal, researchers were initially skeptical. However, upon further investigation, the data indicated characteristics not associated with conventional particles known to mankind.
Recognizing the significance of this finding, the scientists sought to establish the particle’s identity. Theoretical frameworks suggest that dark matter could be composed of WIMPs (Weakly Interacting Massive Particles), axions, or other unknown entities. The particle that passed through Earth seems to fit the criteria established for being a WIMP – particularly concerning its mass and interaction cross-section.
Historical precedents further accentuate the importance of this detection. In the early 20th century, the discovery of the neutron heralded a new era in understanding atomic structure. Similarly, the detection of dark matter would signify an evolutionary leap in cosmology. The concept of dark matter originated from the work of Fritz Zwicky in the 1930s when he observed anomalies in the motion of galaxies within clusters. Over the years, numerous indirect pieces of evidence have emerged, yet direct detection had remained elusive until now.
The particle’s journey through Earth provides a unique opportunity for researchers to study its properties without the hindrance of atmospheric noise that typically complicates cosmic particle detection. By analyzing the signals captured by the underground detectors, scientists aim to glean insight into the particle’s mass, interaction rate, and possibly its decay products. If the particle aligns with theoretical models of dark matter, it would validate years of astrophysical predictions while also laying the groundwork for new explorations into the fundamental forces shaping the universe.
To enhance the accuracy of their findings, researchers from multiple institutions are collaborating, pooling their expertise and technology to decode the implications of this detection. High-energy physicists, astrophysicists, and experts in particle detection technologies are united by the pursuit of understanding this elusive aspect of the universe. The collected data is undergoing rigorous analysis across various research initiatives, promising to transcend the limits of current knowledge surrounding particle physics and dark matter.
Moreover, the implications of such a discovery extend beyond academia. Should these findings be confirmed, they could alter not only theoretical frameworks but also inspire fresh lines of inquiry across multiple scientific disciplines, potentially attracting resources and interests from diverse sectors aimed at revolutionizing our grasp of the universe.
Despite the excitement surrounding the report, researchers emphasize the importance of cautious interpretation. Processes in particle detection are frequently marred by background noise and rare cosmic events that could lead to misinterpretation. Hence, systematic verification through repeated experiments and independent replications is paramount to cement the claim of dark matter detection.
If validated, the potential discovery of dark matter could have profound implications for our understanding of the universe itself. Dark matter is hypothesized to play a critical role in structure formation, influencing the gravitational dance of galaxies and cosmic filaments. Recognizing a concrete presence of dark matter would thus reshape not only cosmology but could also foster revolutionary advancements in technologies related to energy production and impact on matter manipulation in general.
Continuing this line of inquiry will necessitate advancements in existing technologies and perhaps the designed construction of new detectors capable of unveiling the nature of dark matter with greater resolution. The current detection method serves as a prototype for similar future initiatives, illustrating how interdisciplinary approaches can lead to remarkable discoveries at the intersection of multiple domains of science.
In conclusion, while further investigation is required to fully ascertain the significance of the particle detected traveling through Earth, the prospect of it being the first successful identification of dark matter offers a tantalizing glimpse into the vast unknowns of our universe. Continued collaboration among scientists combined with advancements in detection technology may soon allow humankind to not only perceive dark matter but comprehend its pivotal role in the cosmic tapestry, ushering in a new era of scientific enlightenment.